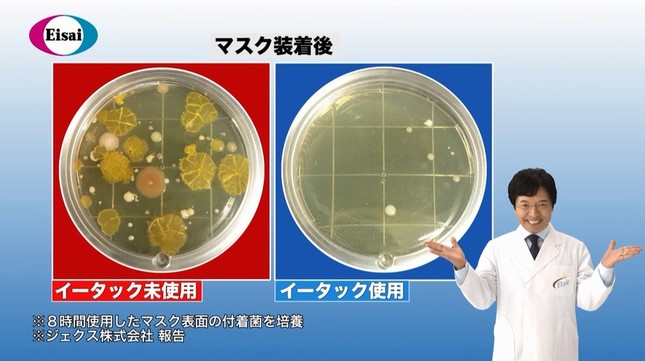

エーザイは2016年11月17日、公式YouTubeチャンネルで「イータック(R)抗菌化スプレー」の宣伝動画を公開した。「イータック(R)抗菌化スプレー」で24時間、ウイルスや菌がマスクに付着するのを防ぐことができる。動画のイメージキャラクターにはサイエンスプロデューサーの米村でんじろうさんが起用された。
マスクの使用頻度はこれから冬にかけて、高まるのは間違いない。マスクには空気中のウイルスや菌が付着しており、でんじろう先生は動画で「あなたのマスクは大丈夫ですか」と問いかける。エーザイでは、1日(8時間)使用したマスクの表面の付着物を培養器に入れると、多くの菌がいると分かったという。
でんじろう先生が解決策として挙げたのは、特許抗菌成分「Etak(イータック)」の配合された「イータック(R)抗菌化スプレー」だ。マスクの裏に3、4回だけ噴射すれば、マスク表面のウイルスや菌は除去されて、その持続効果は24時間に及ぶという。実際に商品を使ったマスクと未使用のマスクで8時間過ごし、それぞれを比較すると、使用したマスクには菌がほとんど付いていなかった。
全国のドラッグストア・薬局・薬店で販売中。希望小売価格は1166円(税込)。